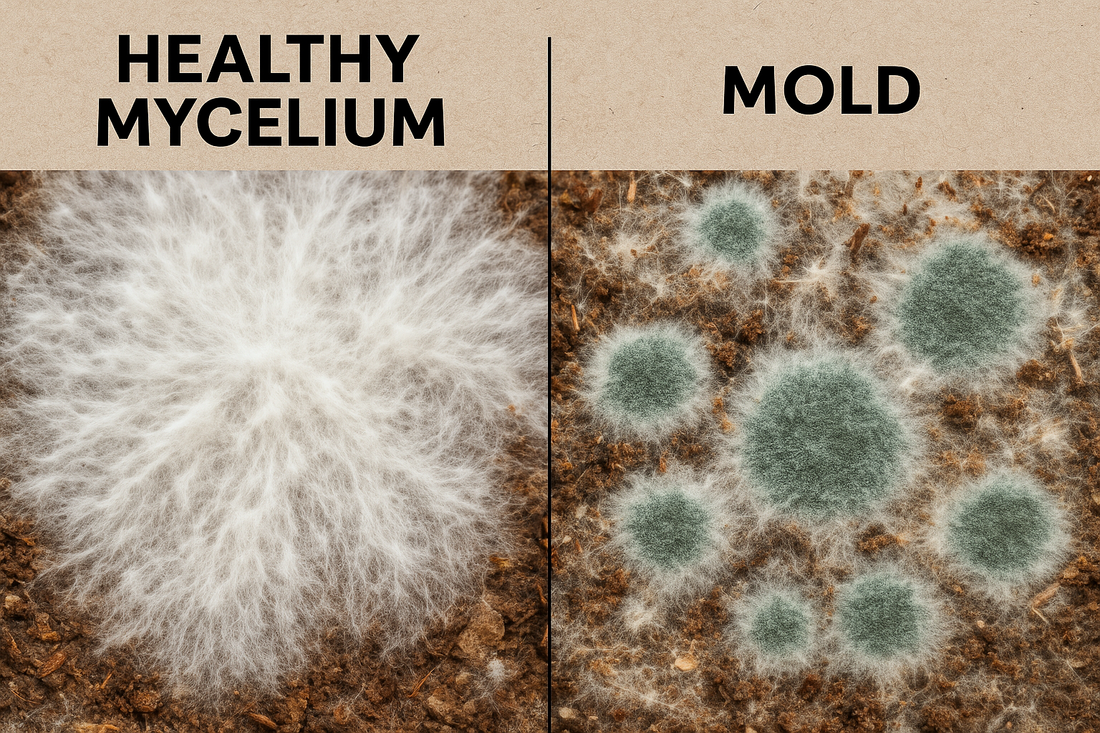
Close-up comparison of healthy white mycelium vs green mold in a mushroom grow bag, showing fluffy rhizomorphic texture and even colonization also showing green mold– Shroom Traders South Charleston WV.

Is This Mold? How to Spot & Prevent Contamination in Your Mushroom Grow (South Charleston, WV Guide)
Share
Is This Mold? How to Spot & Prevent Contamination in Your Mushroom Grow (South Charleston, WV Guide)
By Shroom Traders – Your Local Gourmet Mushroom Experts in South Charleston, West Virginia
Why New Mushroom Growers Worry About Mold
If you’ve ever opened your mushroom grow kit or fruiting block and thought, “Wait… is that mold?”, you’re not alone.
In fact, beginner growers in mushroom forums and Reddit threads like “First time grower. Is this mold?” and “[Contamination] How did I go wrong?” post this question all the time.
Here in South Charleston, WV and across the Appalachian mushroom-growing community, spotting discoloration in your mycelium can be alarming—especially if you’ve invested time and money into your grow.
Healthy Mycelium vs. Contamination: How to Tell the Difference

When growing gourmet mushrooms like lion’s mane, pink oyster, or Italian oyster, it’s important to know the signs of a healthy grow versus a contaminated one.
Healthy Mycelium Usually:
-
Appears bright white and evenly spread
-
Has a fluffy, cottony, or rope-like (rhizomorphic) texture
-
Smells earthy and pleasant, like fresh soil or mushrooms
Possible Contamination Signs:
-
Green, blue, or black spots – often Trichoderma mold
-
Yellow or brown liquid pooling – may be mycelium metabolites (a stress response)
-
Powdery surfaces – potential mold spore development
-
Off or sour smell – bacterial contamination or mold

The “Is This Mold?” Test

While you can’t always diagnose without lab testing, here’s a simple approach for home growers in West Virginia:
-
Observe the Color – True mold often has distinct green, black, or bright blue patches.
-
Check the Texture – Mold tends to look fuzzy or dusty compared to the denser texture of mycelium.
-
Smell It – Healthy mycelium smells like mushrooms; mold smells sharp, musty, or rotten.
-
Watch the Spread – Mold patches usually grow fast and unevenly compared to healthy mycelium colonization.
Common Causes of Mold in Mushroom Grows
In Charleston’s humid summers or during damp Appalachian spring weather, contamination can set in quickly if conditions aren’t right.
Top causes include:
-
Too much moisture and poor airflow
-
Using unsterilized or poorly pasteurized substrate
-
Introducing contaminants when handling your kit or block
-
High spore load in the grow area (especially if growing multiple species)
Can You Save a Contaminated Block?

How to Prevent Mold in Future Grows
Here at Shroom Traders in South Charleston, we teach our participants these simple steps:
-
Start with sterile, high-quality spawn and substrate
-
Keep your grow in a clean, dust-free environment
-
Avoid touching the substrate with bare hands
-
Maintain proper humidity and airflow balance


Local Support for Mushroom Growers in WV
If you’re in South Charleston, WV or anywhere in Appalachia and need help identifying mold in your mushroom grow, we offer:
-
One-on-one contamination troubleshooting
-
Beginner-friendly mushroom growing kits
-
Hands-on mushroom cultivation meetups
-
Free online resources and photo guides
📍 Visit us at ShroomTraders.com or stop by our next mushroom grower meet up in South Charleston!
🧼 Recommended Cleaning Products for a Mold-Free Mushroom Grow
Keeping your grow tent clean is one of the most effective ways to prevent mold from ever getting a foothold. The following tools and cleaners are commonly used by experienced mushroom cultivators to sanitize surfaces, control spores, and protect your hard work.
1. 70% Isopropyl Alcohol – Everyday Sterilizer
This is the go-to surface disinfectant for mushroom growers. At 70% concentration, isopropyl alcohol penetrates cell walls and kills bacteria, mold spores, and other contaminants more effectively than higher concentrations (which evaporate too quickly).
When to Use:
-
Wipe down tent walls, shelving, and tools before every grow.
-
Clean hands (while wearing gloves) before handling substrate or fruiting blocks.
-
Spot-clean during a grow if you notice spills or condensation buildup.
Why It’s Important: Quick-drying, non-residue, and safe around most grow tent materials.
2. Food-Grade Hydrogen Peroxide (3%) – Eco-Safe Mold Control
Hydrogen peroxide breaks down into water and oxygen, making it ideal for mushroom environments where chemical residues can harm mycelium.
When to Use:
-
Mist walls and trays between grows for a deep clean.
-
Treat small patches of surface mold early (before fruiting) to prevent spread.
Why It’s Important: Gentle on equipment, strong against many contaminants, and safe for most organic setups.
3. HEPA-Filtered Vacuum – Spore & Dust Removal
A standard shop vac with a HEPA cartridge filter traps tiny mold spores, dust, and debris instead of blowing them back into the air.
When to Use:
-
Before starting a new grow, to remove dust and any leftover spores.
-
After tearing down a contaminated grow, to ensure no spores linger in the space.
Why It’s Important: Mold spores are microscopic; a HEPA filter keeps them contained instead of recirculating them.
4. Microfiber Cleaning Cloths – Lint-Free Surface Wiping
Microfiber cloths grab and hold onto particles, making them more effective than paper towels for trapping spores and dust.
When to Use:
-
For applying alcohol or peroxide to shelves and tent walls.
-
During routine maintenance to keep surfaces clean without shedding fibers.
Why It’s Important: Reduces cross-contamination risk and leaves surfaces streak-free.
🛠 Pro Cleaning Routine for Mushroom Grow Tents
-
Remove all trays, humidifiers, and equipment.
-
Vacuum tent walls, floor, and shelving with a HEPA vacuum.
-
Wipe all surfaces with 70% isopropyl alcohol (or hydrogen peroxide if preferred).
-
Dry completely before re-assembling.
-
Spot-clean during the grow as needed without over-spraying chemicals on fruiting mushrooms.
Affiliate Disclosure: This post contains affiliate links. As an Amazon Associate, I earn from qualifying purchases. This means if you click a product link and make a purchase, we may receive a small commission at no extra cost to you. This helps support Shroom Traders and allows us to keep providing free mushroom growing tips.
